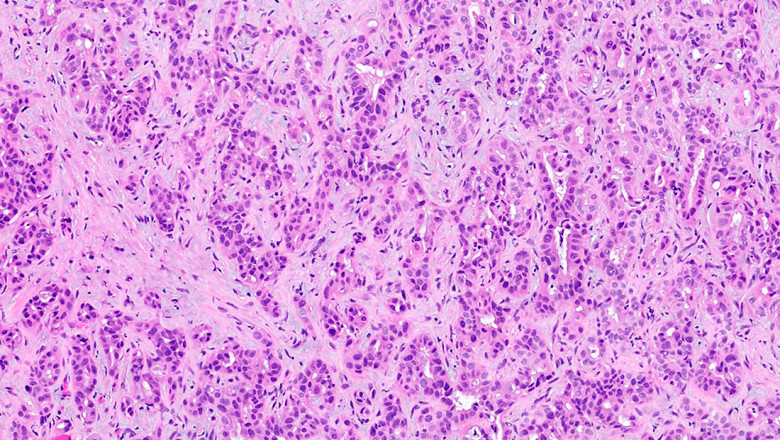

views
Cholangiocarcinoma, also referred to as bile duct cancer, is a type of cancer that develops in the bile ducts. Abdominal pain, yellowish skin, weight loss, generalised itching, and fever are all symptoms of Cholangiocarcinoma. It is also possible to have light-colored stool or dark urine. Gallbladder cancer and cancer of the ampulla of Vater are two other biliary tract cancers. Primary sclerosing cholangitis (an inflammatory disease of the bile ducts), ulcerative colitis, cirrhosis, hepatitis C, hepatitis B, infection with certain liver flukes, and some congenital liver malformations are all risk factors for cholangiocarcinoma. However, the majority of people have no discernible risk factors.
Read more @ https://digitalgrowinfo.blogspot.com/2022/11/a-cholangiocarcinoma-forms-in-ducts.html